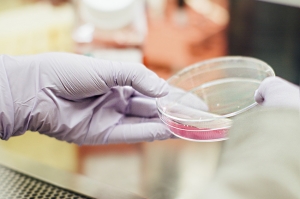

A Hepatite C e o abuso de bebidas alcoólicas correspondem a cerca de 70% a 90% dos casos da doença hepática crônica no mundo ocidental. Aproximadamente 20% dos pacientes com alcoolismo crônico e hepatite C desenvolvem cirrose (estado em que o tecido hepático normal é substituído por tecido fibroso) em um período de 20 a 30 anos. Os relatos de hepatite C que evoluiram para cirrose hepática correspondem a 50% dos casos de transplantes de fígado nos EUA.
A progressão da cirrose em pacientes com hepatite C é afetada por uma série de variáveis. Dados publicados demonstram que genótipos virais e carga viral são fatores importantes para as respostas ao tratamento com interferons. Em relação aos fatores genéticos, há 3 variáveis associadas com a progressão da doença em pacientes infectados pela hepatite C, entre eles: idade de infecção (acima dos 40 anos), abuso de álcool (acima de 50g/dia) e gênero (masculino).
Estudos demonstram que há diferença em relação ao gênero e a diferentes grupos étnicos quanto à gravidade da hepatite C em indivíduos alcoolistas. O status sócio econômico é conhecido como um dos fatores de risco para o HCV e uma das ocorrências mais comuns em pacientes alcoolistas. Africanos, americanos e espanhóis têm uma maior prevalência para a associação entre abuso de álcool e HCV. O HCV é menos comuns em mulheres em relação às doenças autoimunes. Entretanto, as mulheres que consomem bebidas alcoólicas são mais susceptíveis ao desenvolvimento de doenças autoimunes e são menos resistentes ao consumo de bebidas alcoólicas.
Os estudos demonstram que pacientes com HCV que consomem bebidas alcoólicas têm um aumento progressivo do desenvolvimento de fibrose hepática. O estudo mais importante demonstrou que alcoolistas que consomem mais de 30g/dia de álcool por mais de 10 anos têm 3 vezes mais chance de desenvolver cirrose do que um paciente com ou sem hepatite C. Pacientes portadores de hepatite C que consomem mais de 30g/dia de álcool têm 32% mais chance de desenvolver cirrose hepática comparados com aqueles que bebem menos de 30g/dia.
O uso contínuo de álcool pode deprimir os efeitos dos interferons utilizados no tratamento, diminuindo sua eficácia e levando o paciente à piores respostas de tratamento.